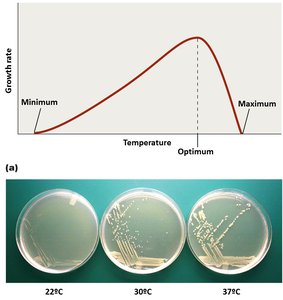
Growth rate vs temperature
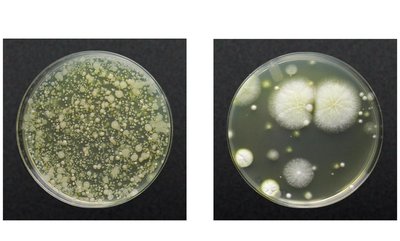
Bacterial and fungal colonies on different agars
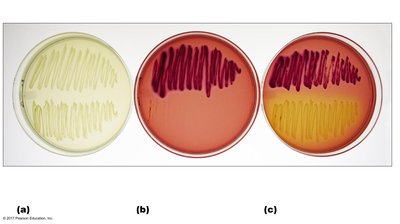
MacConkey agar as selective and differential medium

Back
BackMicrobial Nutrition and Growth: Study Notes for Microbiology Students
Study Guide - Smart Notes

Microbial Nutrition and Growth
Growth Requirements
Microbial growth refers to an increase in the population of microorganisms, not the size of individual cells. Growth depends on the metabolism of nutrients such as carbon, oxygen, nitrogen, and hydrogen, and can result in the formation of discrete colonies or biofilms.
Colony: Aggregation of cells from a single parent cell.
Biofilm: Community of microbes living on a surface.
Growth: Indicates population increase.

Nutrients: Chemical and Energy Requirements
Microorganisms require a source of carbon, energy, and electrons or hydrogen atoms. These requirements define their nutritional classification.
Autotrophs: Use CO2 as carbon source.
Heterotrophs: Catabolize organic molecules from other organisms.
Chemotrophs: Use chemicals as energy source.
Phototrophs: Use light as energy source.
Organotrophs: Acquire electrons from organic sources.
Lithotrophs: Acquire electrons from inorganic sources.

Limiting Nutrient: The absence of a required nutrient can halt metabolism and growth.
Oxygen Requirements
Microorganisms differ in their oxygen requirements, which are determined by their metabolic pathways and ability to detoxify reactive oxygen species.
Obligate aerobes: Require oxygen as final electron acceptor.
Obligate anaerobes: Cannot tolerate oxygen; use other electron acceptors.
Facultative anaerobes: Can use fermentation or anaerobic respiration.
Aerotolerant anaerobes: Do not use aerobic metabolism but can detoxify oxygen.
Microaerophiles: Require low oxygen levels (2–10%).

Toxic Forms of Oxygen
Reactive oxygen species can damage cellular components. Microbes possess enzymes to detoxify these forms.
Singlet oxygen (O2): Highly reactive; removed by carotenoids.
Superoxide radicals (O2–): Detoxified by superoxide dismutases.
Peroxide anion (O22–): Catalyzed by catalase.
Hydroxyl radicals (OH–): Most reactive; formed by ionizing radiation.


Catalase Reaction:
Nitrogen Requirements
Nitrogen is a growth-limiting nutrient required for amino acids and nucleotides. Most cells recycle nitrogen, but only certain bacteria can fix atmospheric nitrogen.
Nitrogen fixation: Conversion of N2 gas to usable forms by bacteria.
Acquisition: From organic and inorganic sources.

Other Chemical Requirements
Microorganisms require additional elements and growth factors for proper metabolism.
Elements: Phosphorus, sulfur, calcium, manganese, magnesium, copper, iron.
Trace elements: Selenium, zinc (required in small amounts).
Growth factors: Organic molecules not synthesized by certain organisms (e.g., vitamins).

Physical Requirements
Physical factors such as temperature, pH, and water availability affect microbial growth.
Temperature: Influences protein structure and membrane fluidity. Microbes are classified by their temperature preferences.
pH: Affects hydrogen bonding and enzyme activity. Microbes are classified as neutrophiles, acidophiles, or alkalinophiles.
Water: Essential for dissolving nutrients and metabolic reactions. Osmotic and hydrostatic pressure are important for certain microbes.

Associations and Biofilms
Microorganisms often live in associations with other species, forming complex communities called biofilms. These associations can be antagonistic, synergistic, or symbiotic.
Biofilms: Complex associations of microorganisms attached to surfaces via a sticky extracellular matrix.
Quorum sensing: Bacteria communicate and coordinate behavior based on population density.
Benefits: Protection from drugs, division of labor, increased virulence.

Clinical Case Study: Dental Biofilm
Dental plaque is a biofilm that can lead to tooth destruction and systemic infections. Proper oral hygiene and professional care are essential to prevent biofilm-related diseases.
Effects: Tooth destruction, bacterial invasion, malnutrition, pain.
Treatment: Removal of plaque, antibiotics, dental restoration.

Culturing Microorganisms
Microbiologists culture microorganisms by transferring samples (inoculum) into nutrient media. Proper labeling and transport are essential for clinical samples.
Liquid media (broths): Bacteria grow in suspension.
Solid media (agar): Bacteria form colonies on the surface.
Obtaining Pure Cultures
Pure cultures are obtained by isolating suspected pathogens from mixed samples using sterile techniques.
Streak-plate method: Inoculum is spread across the surface to isolate colonies.
Pour-plate technique: Used for protozoa and algae; involves serial dilutions.

Culture Media
Microorganisms have diverse nutritional requirements, necessitating different types of culture media.
Defined (synthetic) media: Precise chemical composition; used for fastidious organisms.
Complex media: Contains partially digested materials; enriched media includes specific growth factors.
Selective media: Favors growth of certain microbes or inhibits others.
Differential media: Allows visible changes to distinguish between organisms.
Anaerobic (reducing) media: Removes oxygen for anaerobic growth.
Transport media: Maintains viability during specimen transport.

Special Culture Techniques
Some microorganisms require specialized techniques for cultivation.
Animal and cell culture: Used for viruses and fastidious microbes.
Low-oxygen culture: Carbon dioxide incubators and candle jars.
Preserving Cultures
Microbial cultures can be preserved by slowing metabolism.
Refrigeration (4°C): Short-term storage.
Deep-freezing (-80°C): Long-term storage.
Lyophilization: Freeze-drying for decades-long preservation.



Growth of Microbial Populations
Most microbes reproduce by binary fission, resulting in exponential population growth. Generation time is the period required for a population to double.
Binary fission: Cell grows, replicates DNA, and divides into two daughter cells.
Generation time: Typically 1–3 hours; optimal conditions can reduce this to 20 minutes.

Mathematical Considerations in Population Growth
Microbial populations grow logarithmically. The number of cells after n generations is calculated as:
Exponential growth: where n = number of generations.
Phases of Microbial Population Growth
A typical microbial growth curve has four distinct phases, plotted on a semilogarithmic scale.
Lag phase: Adjustment, no growth.
Log (exponential) phase: Active growth.
Stationary phase: Rate of cell production equals rate of cell death.
Death (decline) phase: Cell death exceeds cell production.

Continuous Culture in a Chemostat
A chemostat is an open system device that maintains cultures in a specific growth phase by supplying fresh medium and removing spent medium.
Industrial application: Constant production of microbial products.

Measuring Microbial Reproduction
Microbial population size is estimated using direct and indirect methods.
Direct methods: Cell counters (Petroff-Hausser chamber), electronic counters (Coulter counter, flow cytometry), serial dilution and viable plate counts, membrane filtration, most probable number.
Indirect methods: Turbidity (spectrophotometry), metabolic activity, dry weight, genetic methods.

Summary Table: Microbial Growth Phases
Phase | Description |
|---|---|
Lag | Adjustment, no growth |
Log | Active growth, exponential increase |
Stationary | Growth rate equals death rate |
Death | Death rate exceeds growth rate |
Additional info: Where original content was brief, academic context was added to clarify definitions, examples, and applications. All included images directly reinforce the adjacent explanations.
